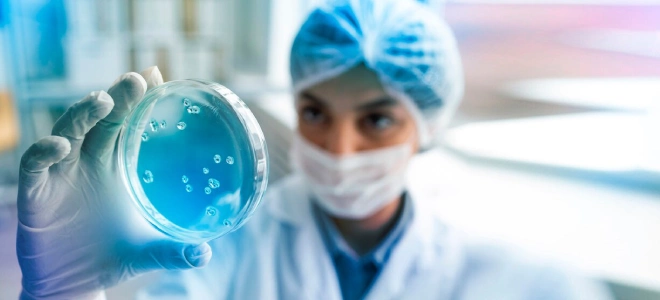
Client Name

Policy
Quality Policy
Over the years our name has become synonymous with quality to our customers.
- We focus on constant endeavours for improvement of yield and Quality of our products.
- We Work very closely with our customers to understand their needs and make sure that we not only fulfill their requirements but exceed their expectations.
- We have a pro-active, system oriented team approach with suppliers and customers in order to develop them as business partners.